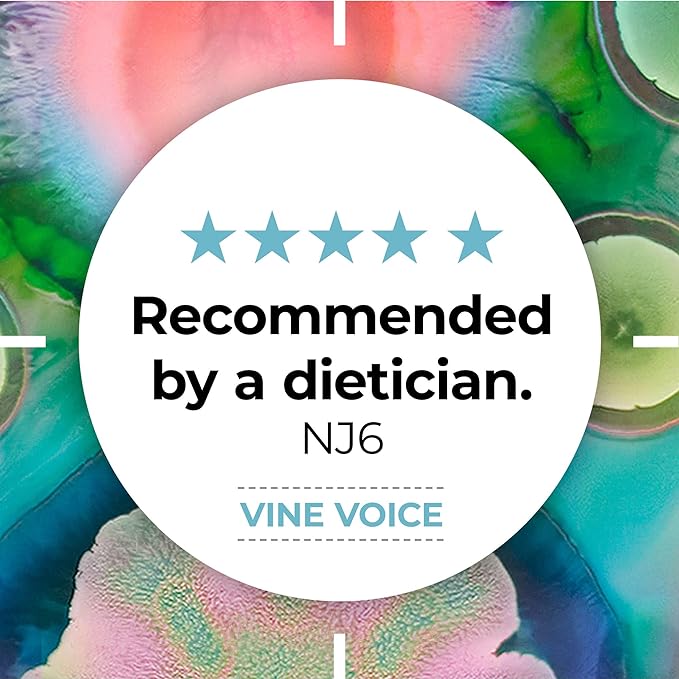

Alflorex Probiotics Chewable 30 Tablets
Alflorex Probiotics Chewable 30 Tablets
Convenient Chewable Gut Support for Daily Digestive Comfort
Support your gut health with a tasty, chewable probiotic designed to help maintain digestive balance and reduce bloating — perfect for those who prefer an alternative to capsules.
Quick Highlights
- 30 chewable tablets (1-month supply)
- Contains Bifidobacterium longum 35624® strain
- No need to swallow capsules
- Supports gut health & digestive comfort
- Helps reduce bloating and discomfort
- Great-tasting chewable format
- One tablet daily
Overview
Alflorex Probiotics Chewable offers the same trusted gut support as the original capsule — now in a convenient chewable tablet.
Formulated with the clinically researched Bifidobacterium longum 35624® strain, it helps maintain a balanced gut microbiome, supporting digestive comfort and reducing symptoms such as bloating and abdominal discomfort.
Ideal for those who prefer a simple, easy-to-take probiotic without swallowing capsules.
Why Choose Alflorex Chewable
- Same clinically researched strain in chewable form
- Easy and convenient alternative to capsules
- Supports digestive balance and comfort
- Helps reduce bloating and irregularity
- Encourages consistent daily use
- Trusted Alflorex quality
Who It’s For
- Individuals who dislike swallowing capsules
- Those with bloating or digestive discomfort
- People looking for daily gut support
- Individuals with busy lifestyles
- Anyone wanting a simple probiotic routine
What It Helps Support
- Gut microbiome balance
- Digestive comfort and regularity
- Reduction in bloating and discomfort
- Support for sensitive digestion
- Overall gut health and wellbeing
Ingredients (Per Daily Dose)
- Bifidobacterium longum 35624® – approx. 1 billion CFU
Nutritional Information
| Component | Amount |
|---|---|
| Probiotic Culture | ~1 Billion CFU |
| Format | Chewable Tablets |
How to Use
Chew 1 tablet daily. Do not swallow whole.
When to Use
- Daily for ongoing gut health support
- During digestive discomfort
- As part of a wellness routine
- For convenient, on-the-go use
Safety Information
- Do not exceed the recommended daily dose
- Food supplements should not replace a varied diet
- Excessive consumption may produce laxative effects
- Consult your doctor if pregnant, breastfeeding, or on medication
- Keep out of reach of children
FAQs
1. Is this as effective as the capsule version?
Yes, it contains the same clinically researched strain.
2. Do I need to chew it?
Yes, it is designed to be chewed, not swallowed whole.
3. Does it taste good?
Yes, it has a pleasant chewable format.
4. Does it help with bloating?
Yes, it supports digestive comfort.
5. Can I take it daily?
Yes, it is designed for ongoing use.
6. Does it need refrigeration?
No, it is shelf-stable.
7. Is it suitable for vegetarians?
Yes, it is suitable for vegetarians.
8. How long before results show?
Typically 2–4 weeks.
9. Can I take it with other supplements?
Yes, it pairs well with most supplements.
10. Is it suitable for children?
Check label guidance or consult a professional.
11. Can I switch from capsules to chewables?
Yes, they provide the same core benefit.
12. Who is this best for?
Anyone wanting a simple, chewable probiotic option.
Product Details
- Brand: Alflorex
- Product Type: Chewable Probiotic Supplement
- Pack Size: 30 Tablets
- Format: Chewable Tablets
- Suitable For: Adults
Thank you for using our site.
Online/In-store Price Match Guarantee Policy
We guarantee that the prices available on our site www.lirpharmacy.com are also available in Plaza Pharmacy, Unit 2, The Plaza, Swords, Co Dublin. We look forward to meeting you in person! We guarantee that customers can purchase a product in store for the price displayed on our website.
Free Click & Collect
We offer a FREE click & collect service through our pharmacy in Swords Village:
Plaza Pharmacy, Unit 2 The Plaza, Swords, Co Dublin K67 X7P6, Ireland
Delivery with DPD
We deliver to Ireland, Northern Ireland and the European Union with DPD.
You will receive a text message or email from DPD on the day of your delivery with an estimated time for delivery of your order.
DPD offer a Parcel Wizard service that allows you to choose a day and location that suits you to have your parcel delivered.
You may register for this service at www.dpdparcelwizard.ie/Register
Please allow 2 to 7 working days for your order to be delivered. We fulfill the majority of our orders within 16 hours.
In the unlikely event that the item that you ordered is not in stock, we will issue your account with a refund and send the remaining items in your order.
Returns
We offer a free returns service with DPD. To physically return parcels please use the DPD Pickup Parcelshop site https://dpd.ie/Returns#/
The DPD Parcelshop service has over 600 nationwide collection points that returns may be dropped to. Please include your order number as the DPD reference number.
Returns for eligible products can be made within 14 days of the item being delivered.
If you have any queries or require assistance please contact us at info@lirpharmacy.com
Shipping costs & delivery
- We deliver free of charge to Ireland & Northern Ireland for orders of €50 or more.
- We deliver free of charge to Austria, Belgium, Czech, Denmark, France, Germany, Luxembourg, Netherlands & Poland for orders of €100 or more.
- We deliver to all other countries free of charge for orders of €200 or more.
| Order Value | Rate | Order Value | Rate | # Days | ||||
| Ireland | >€50 | Free | <€50 | €5.99 | 2 to 7 | |||
| Northern Ireland | >€50 | Free | <€50 | €5.99 | 2 to 7 | |||
| Austria | >€100 | Free | <€100 | €13.99 | 4 | |||
| Belgium | >€100 | Free | <€100 | €11.99 | 3 | |||
| Czech Republic | >€100 | Free |
<€100 |
€13.99 | 5 | |||
| Denmark | >€100 | Free | <€100 | €13.99 | 4 | |||
| France | >€100 | Free | <€100 | €11.99 | 3 | |||
| Germany | >€100 | Free | <€100 | €11.99 | 3 | |||
| Luxemburg | >€100 | Free | <€100 | €11.99 | 3 | |||
| Netherlands | >€100 | Free | <€100 | €11.99 | 3 | |||
| Poland | >€100 | Free | <€100 | €13.99 | 5 | |||
| Hungary | >€200 | Free | <€200 | €15.99 | 5 | |||
| Lithuania | >€200 | Free | <€200 | €15.99 | 5 | |||
| Slovakia | >€200 | Free | <€200 | €15.99 | 5 | |||
| Estonia | >€200 | Free | <€200 | €15.99 | 5 | |||
| Italy | >€200 | Free | <€200 | €15.99 | 5 | |||
| Latvia | >€200 | Free | <€200 | €15.99 | 5 | |||
| Sweden | >€200 | Free | <€200 | €15.99 | 5 | |||
| Croatia | >€200 | Free | <€200 | €30.99 | 6 | |||
| Portugal | >€200 | Free | <€200 | €30.99 | 6 | |||
| Finland | >€200 | Free | <€200 | €30.99 | 6 |